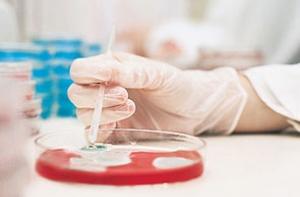
Ученые нашли «неубиваемую» бактерию

Читайте нас также
Супербактерия с геномом NDM-1, обнаруженная в Нью-Дели, способна расщеплять самые сильные антибиотики. Медики опасаются, что ее свойства передадутся опасным вирусам, которые станут еще более трудноизлечимыми.
Геном был назван в честь столицы Индии, где он и был обнаружен впервые. Бактерии с NDM-1 были найдены в водопроводной воде, лужах и стоках Нью-Дели, сообщает сайт газеты «Труд». Из Индии супербактерии уже попали в Великобританию, Францию, Бельгию, США, Канаду и Австралию.

На данный момент сама бактерия безвредна для человека. Опасение ученых вызывает то, что разрушительный ген способен легко передаваться новым бактериям, в том числе тем, которые вызывают серьезные заболевания. Например, это может привести к созданию новых устойчивых форм холеры и дизентерии.
В изучении бактерии с геномом NDM-1 Индии обещала оказать помощь Всемирная организация здравоохранения. «Всемирная организация здравоохранения поможет индийскому правительству исследовать ген NDM-1 и выяснить, представляет ли супербактерия опасность для здоровья», – цитирует главу представительства ВОЗ Нату Манабде РИА Новости.
Всемирная организация здравоохранения ранее уже выражала тревогу по поводу антимикробной резистентности, которая возникает благодаря злоупотреблению антибиотиками.
Как уже писали Дни.Ру, в августе 2010 года бактерии с геномом NDM-1 были обнаружены в Великобритании. На тот момент было зафиксировано около 50 случаев заражения человека устойчивой к антибиотикам бактерией.